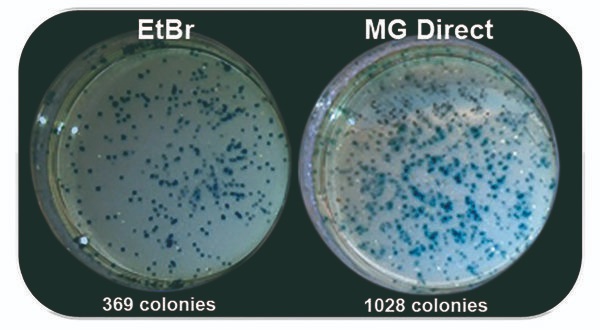

- Home
- Companies
- Nippon Genetics Europe
- Products
- Nippon Midori Green Direct - Model MG06 ...

Nippon Midori Green Direct - Model MG06 -Safe DNA/RNA Electrophoresis Stain
Safe DNA/RNA stain added directly to the samples with loading dye included. MIDORI Green Direct is a safe alternative to ethidium bromide for visualization of double-stranded DNA, single-stranded DNA, and RNA in agarose gels. In contrast to most other non-ethidium bromide based dyes, MIDORIGreen Direct is just added to your samples. The loading dye is already included. You do not need to add any other loading dye to both gel matrix and running buffers
- Direct Staining of DNA/RNA
- No toxicity, non-carcinogenic
- Safe alternative of Ethidium Bromide
- Loading Dye is included
- Very low Background
Get the best signal to noise ratio
The direct staining of the DNA rather than the gel eliminates the background staining providing a perfect signal (Fig. 1). MIDORIGreen Direct was developed to work with Blue Light LED illuminators, but you can also use it with a regular UV transilluminator.

The isolation of DNA from agarose gels enables downstream applications. It is well known that many dyes, such as ethidium bromide or even SYBR™ Green are strong enzyme inhibitors due to their intercalating properties. MIDORI Green dyes bind to the DNA backbone. This results in a much higher efficiency for downstream applications, i.e. cloning (Fig. 2), seqeuncing, PCR, etc.
MIDORI Green Direct stain is non-carcinogenic and less mutagenic compared to ethidium bromide. Furthermore, we can state that MIDORI Green Direct is impenetrable to latex gloves and cell membranes.
MIDORI Green Direct is classified as non-hazardous to aquatic life, under CCR Title 22 regulation. Thus, small amounts of MIDORI Green Direct stain can be safely released into the environment.
- Ames-Test
- Cytotoxicity
- Cell membrane Permeability
- Hazardous Waste Screening
- Latex and Nitrile Gloves Penetration
Loading Dye
MIDORI Green Direct stains are provided in a form of 10X sample loading dyes and they are to be added to your samples only. You do not need to add any other dyes to the gel matrix nor to the running buffers.
Free sample
Product of interest*
- MIDORI Green Advance (for UV-light or Blue/Green LEDs, in-gel or post staining)
- MIDORI Green Direct (for Blue/Green LEDs, direct DNA/RNA staining)
- MIDORI Green Xtra (for Blue/Green LEDs, in-gel or post-staining)
- MIDORI Green Easy


- Prepare the agarose solution
- Mix gently without having air bubbles
- Let the solution cool down to 60-70°C and cast the gel
- Mix samples and DNA markers with MIDORI GREEN DIRECTstain at 1:10 (dye:sample) dilution rate
- After the electrophoresis, view and document your results as you would do with Ethidium Bromide staining protocols.View the results under traditional UV light after electrophoresis or use non hazardous FastGene® Blue-LED-Transilluminator or the FastGene® Blue/Green-LED-Transilluminator for the best signal.
MIDORI Green Direct is optimized for blue/green and blue LED light, leading to very good fluorescence signals of DNA and RNA in agarose gels. MIDORI Green Direct was developed for direct staining of nucleic acids.

